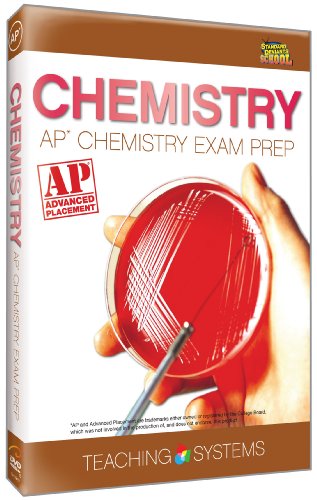

member goods, events, publications
No other members have written about this topic: "'ASA Test Prep Board'". Lucky you!! This is an opportunity to be discovered by
associating these search terms with your next notem.
listens & views

PREP & LANDING: NAUGHTY VS ...
by PREP AND LANDING: NAUGHTY VS NICE / (SUB WS)
DIGITAL VIDEO DISC$16.99

AP ENGLISH LANGUAGE & COMPOSITION ...
by AP ENGLISH LANGUAGE AND COMPOSITION EXAM PREP
DIGITAL VIDEO DISC$42.49